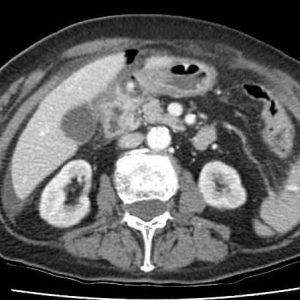
Thủng môn vị

TIÊU HOÁ
Hiển thị 821–840 của 1445 kết quảĐã sắp xếp theo mới nhất
-

U dạ dày
Lượt xem: 195» 19-09-2019 -

U dạ dày
Lượt xem: 154» 19-09-2019 -

U dạ dày
Lượt xem: 162» 19-09-2019 -

U dạ dày
Lượt xem: 136» 19-09-2019 -

U dạ dày
Lượt xem: 171» 19-09-2019 -

U dạ dày
Lượt xem: 193» 19-09-2019 -

Thủng tạng rỗng
Lượt xem: 388» 14-09-2019 -

Thoát vị hoành
Lượt xem: 200» 13-09-2019 -

Phình TM cửa
Lượt xem: 130» 11-09-2019 -

Sa hậu môn nhân tạo
Lượt xem: 146» 10-09-2019 -

Thủng tạng rỗng
Lượt xem: 302» 09-09-2019 -

Vỡ cơ hoành
Lượt xem: 149» 08-09-2019 -

Vỡ cơ hoành
Lượt xem: 158» 08-09-2019 -

Vỡ cơ hoành
Lượt xem: 289» 08-09-2019 -

Vỡ cơ hoành
Lượt xem: 148» 08-09-2019 -

Vỡ cơ hoành
Lượt xem: 55» 08-09-2019 -

Vỡ cơ hoành
Lượt xem: 139» 08-09-2019 -

Vỡ cơ hoành
Lượt xem: 167» 08-09-2019 -

FNH
Lượt xem: 134» 08-09-2019 -

Khí tự do ổ bụng
Lượt xem: 197» 07-09-2019